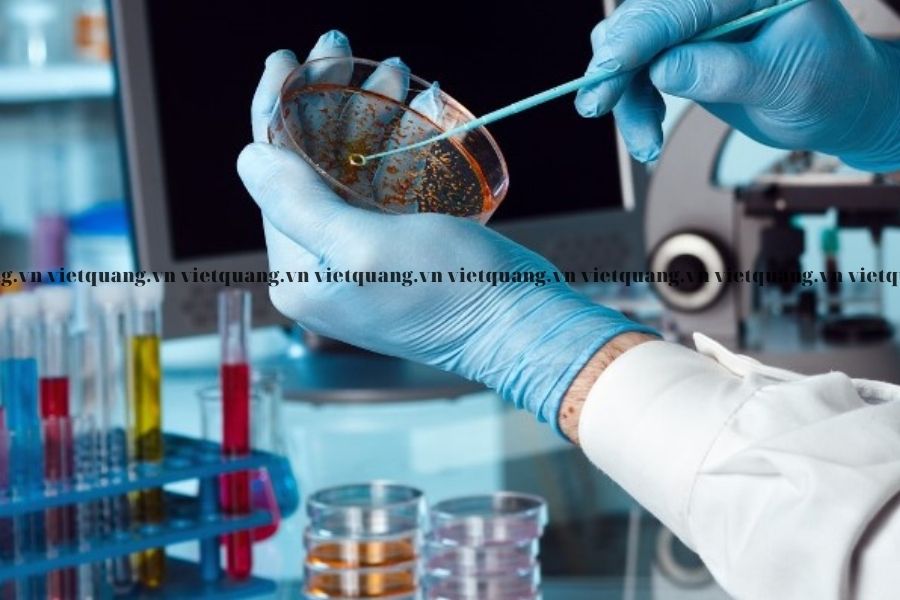

Cồn IPA là gì?
Cồn Ipa hay còn được gọi là dung môi IPA (Iso propyl alcohol), cồn isopropyl là một hợp chất hóa học không màu, dễ cháy, có mùi nồng đặc trưng của rượu và độ bay hơi cao. Công thức phân tử của cồn IPA là: C3H8O. Cồn IPA có khả năng tan vô hạn trong nước và có thể hòa tan rất nhiều loại dung môi hữu cơ, dầu alkaloids, nướu và nhựa tự nhiên. Vì vậy nó được ứng dụng rất rộng rãi trong nền công nghiệp hiện nay.
Lịch sử hình thành và các phương pháp sản xuất Cồn IPA.
Từ năm 1920, Công ty Standard Oil của Mỹ lần đầu tiên sản xuất Cồn IPA bằng cách hydrat hóa trực tiếp Propene với nước để sử dụng trong thế chiến thứ nhất.
Đến năm 1994: Cồn IPA được sản xuất rộng rãi với sản lượng 1.5 triệu tấn tại Mỹ, Châu Âu và Nhật Bản.
Cồn IPA hiện nay được sản xuất bằng 3 phương pháp:
-
Hydrat hóa trực tiếp: Là phản ứng giữa Propene với nước ở thể lỏng hoặc thể khí trong điều kiện áp suất cao và có sự góp mặt của các chất xúc tác rắn hoặc acid hỗ trợ. Phương pháp này yêu cầu propene có độ tinh khiết cao > 90% và được sản xuất chủ yếu ở Châu Âu.
-
Hydrat hóa gián tiếp: Là quá trình phản ứng giữa propene với acid sulfuric để tạo thành một hỗn hợp các este sulfat sau đó thủy phân este này bằng hơi nước để cho ra IPA và sau đó đem đi chưng cất. Phương pháp này có ưu điểm có thể sử dụng propene chất lượng thấp và tạo ra sản phẩm phụ là Diisopropyl ethe có thể tái chế trở lại quy trình và thủy phân để cho ra sản phẩm mong muốn.
-
Hydro hóa acetone: Là quá trình acetone thô được hydro hóa trong pha lỏng trên niken Raney hoặc hỗn hợp đồng và oxit crom để tạo ra Isopropyl Alcohol.
Ứng dụng của cồn IPA
-
Cồn IPA được sử dụng làm chất trung gian: Cồn IPA được ester hóa để tạo ra isopropyl acetate một dung môi khác. Cồn IPA còn phản ứng với carbon disulfide và natri hydroxit để tạo ra natri isopropylxanthate là một loại thuốc diệt cỏ. Ngoài ra IPA khi phản ứng với nhôm hoặc titanium tetrachloride sẽ cho ra hợp chất dùng làm xúc tác cho công nghiệp và thuốc thử hóa học.
-
Cồn IPA làm dung môi: Cồn IPA có khả năng hòa tan vô hạn trong nước và hòa tan rất nhiều loại dung môi hữu cơ và dầu, vì vậy nó được dùng như một dung môi và chất tẩy rửa, đặc biệt là dùng trong các ứng dụng hòa tan dầu mỡ, có thể hòa tan được nhiều hợp chất không phân cực mà các dung môi khác không làm được.
- Cồn IPA được sử dụng như một chất dung môi cho nhiều loại nhựa, tốc độ bay hơi nhanh của cồn IPA nên được sử dụng như một chất kháng đục trong quá trình sản xuất sơn. Cồn IPA được dùng trong vài loại sơn nhất định để thay thể cho ethanol mà không làm thay đổi tính chất của sơn. Một lượng nhỏ isopropyl cũng có thể hòa tan đáng kể nitrocellulose, không những thế isopropyl alcohol có khả năng hòa tan nhựa rất tốt.
-
Cồn IPA làm chất chống đông: Nó là một hợp chất giúp hạn chế quá trình đóng băng trong mùa đông của dầu mỏ. Và ngoài ra còn được sử dụng trong các ứng dụng làm lạnh các chất trong tủ lạnh, máy điều hòa.
-
Trong Y học: Cồn IPA 75% được ứng dụng rộng rãi trong y học làm chất sát trùng ngoài ra nó còn được dùng để làm khô tai, chống viêm tai thường dùng cho các vận động viên bơi lội.

-
Trong nền công nghiệp xe hơi: Cồn IPA là thành phần chính trong nhiên liệu làm khô khí. Với sự có mặt của một hàm lượng nước nhất định sẽ gây ra những sự cố cho các bồn chứa nhiên liệu, Cồn IPA không loại bỏ nước mà sẽ đóng vai trò như một dung môi trung gian có tác dụng hòa tan nước, hòa lẫn vào trong nhiên liệu, do đó nước sẽ không gây ra những sự cố nêu trên.

+ Ngoài ra cồn IPA với hàm lượng 35 – 50% kết hợp với nước tạo ra chất tẩy rửa kính và dung dịch xà phòng tẩy rửa hiệu quả.
-
Sản xuất mỹ phẩm: Cồn IPA được dùng làm nguyên liệu trong nước hoa hoặc sản xuất các loại mỹ phẩm có hương thơm.
-
Trong phòng thí nghiệm: Cồn IPA được sử dụng là một chất bảo quản mẫu vật sinh học, Cồn IPA cung cấp một lựa chọn tương đối không độc hại formaldehyde và các chất bảo quản tổng hợp khác. Giải pháp isopropyl alcohol 90-99% được sử dụng để bảo quản mẫu vật. Ngoài ra cồn IPA còn thường được sử dụng trong khai thác DNA. Nó được thêm vào một giải pháp DNA để tủa DNA thành một viên sau khi ly tâm các DNA. Điều này có thể vì ADN là không hòa tan trong cồn isopropyl.
Mua Cồn IPA ở đâu giá tốt?
Hiện nay có rất nhiều địa chỉ bán Cồn IPA trên thị trường, nhưng để lựa chọn một đơn vị cung cấp uy tín, nhãn mác đầy đủ, đảm bảo chất lượng, giá cả hợp lý… thì vẫn là vấn đề khó khăn đối với rất nhiều người. Và Hóa chất công nghiệp Việt Quang với hơn 15 năm uy tín trên thị trường xin khẳng định sẽ là một lựa chọn tốt dành cho bạn. Chúng tôi cam kết:
-
Hàng hóa chất lượng tốt
-
Đảm bảo cung cấp đủ mọi khối lượng theo yêu cầu
-
Giá thành cạnh tranh nhất thị trường
-
Thời gian giao hàng nhanh, hỗ trợ giao hàng toàn quốc
-
Hàng hóa được vận chuyển an toàn, đảm bảo không xảy ra hư hỏng hay lỗi.
-
Dịch vụ hậu bán hàng tốt, luôn hướng đến sự hài lòng và lợi ích của khách hàng.
Nếu bạn có nhu cầu mua hóa chất, hãy tham khảo tại: Hóa chất Việt Quang để biết thêm thông tin về đặc tính sản phẩm, giá cả và chính sách ưu đãi.
Ms Thu: 0902 625 629

